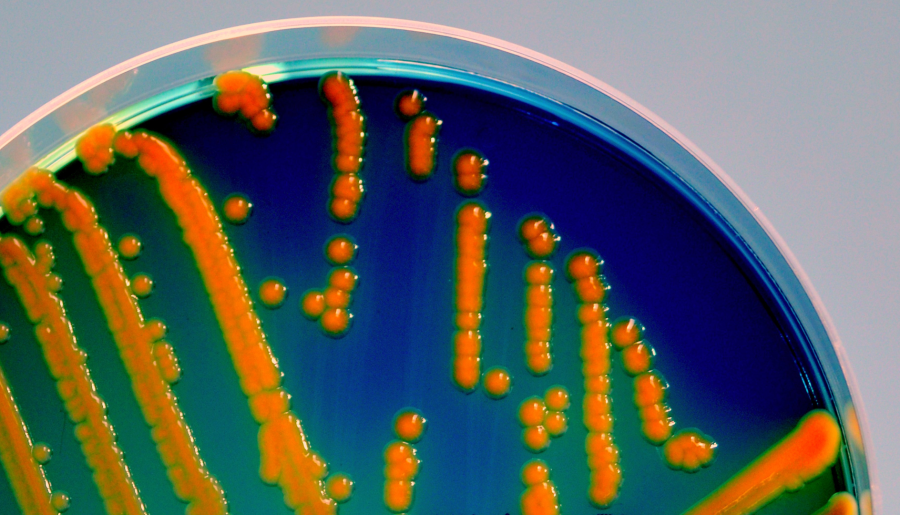
A Escherichia coli pode causar infeccións intestinais e extraintestinais en humanos e animais

Saskia Flament: «Para garantir a seguridade alimentaria, é necesario realizar controis microbiolóxicos ao longo de toda a cadea alimentaria»

Conceptos como ‘One Health’ (Unha Saúde) ou ‘From Farm to Fork’ (Da Granxa á Mesa) están a cobrar cada vez máis relevancia no panorama científico, político e social. Avogar por unha idea de saúde global que teña en conta as necesidades ambientais, humanas e animais non se articula como unha opción, se non como unha indiscutible necesidade.
Da mesma forma, dotar á seguridade alimentaria dun carácter transversal no que cada elo da cadea alimenticia sexa analizado e controlado, permite avanzar cara a sistemas alimentarios xustos, saudables e sostibles.
Como un dos obxectos de estudo protagonistas entre estas dúas estratexias, podemos situar á Escherichia coli, unha bacteria que forma parte da microbiota do noso tracto gastrointestinal e doutros mamíferos e que en numerosas ocasións pode actuar como axente patóxeno polo consumo de alimentos contaminados.
De feito, nun recente estudo publicado na revista médica británica The Lancet, relacionábase a E. coli con arredor de 950.000 mortes no ano 2019. Por iso, o seu estudo, caracterización e control resultan tan críticos á hora de minimizar o seu impacto na saúde pública e afianzar un modelo alimentario seguro.
Premio extraordinario de doutoramento en Ciencias da Saúde pola Universidade de Santiago de Compostela, investigadora contratada no Campus Terra e membro do Laboratorio de Referencia de Escherichia coli (LREC) da USC, hoxe falamos con Saskia Flament Simon sobre as características que fan da E. coli un obxecto de estudo de tanta relevancia, o papel da estratexia ‘Da Granxa á Mesa’ e a problemática da crecente resistencia bacteriana aos antibióticos.
-Nos seus traballos de investigación hai unha clara protagonista: a Escherichia coli. Que fai desta bacteria un obxecto de estudo tan relevante?
-Escherichia coli é unha bacteria cunha notable variabilidade xenética, existindo cepas comensais e cepas patóxenas. Isto é debido á presenza de determinados xenes que lle confiren características virulentas e/ou de resistencia aos antibióticos. Ademais, esta bacteria pode causar infeccións intestinais e extraintestinais en humanos e animais, sendo un axente infeccioso moi prevalecente e causante de zoonoses.
-Na mesma liña, vostede é membro do Laboratorio de Referencia de Escherichia coli (LREC) da USC. Que papel xogan este tipo de grupos de investigación en ámbitos de estudo como o seu?
-O Laboratorio de Referencia de Escherichia coli (LREC), dirixido polo investigador Jorge Blanco, posúe unha ampla experiencia na caracterización de cepas patóxenas de E. coli. Participou na análise de alimentos dentro do ámbito da seguridade alimentaria e no diagnóstico clínico de mostras biolóxicas humanas e animais, cando se sospeita que o axente causal é E. coli. Ademais, o LREC colabora activamente co Hospital Universitario Lucus Augusti (HULA), para investigar as infeccións causadas por E. coli na poboación de Lugo. É fundamental contar con programas de vixilancia e seguimento epidemiolóxico destas infeccións para poder establecer medidas preventivas adecuadas, especialmente ante o alarmante incremento de cepas multirresistentes aos antibióticos.
-A detección da E. coli en alimentos e auga contaminados é clave para que exista unha seguridade alimentaria con garantías. Cales son os últimos avances nesta materia? Que papel xoga o desenvolvemento e utilización de kits para o serotipado destas bacterias?
-Hoxe en día, as bases de datos públicas conteñen un impresionante número de xenomas bacterianos completamente secuenciados grazas ao desenvolvemento das novas tecnoloxías de secuenciación. Sen dúbida, no noso campo de investigación, así como noutros, os recursos bioinformáticos e a intelixencia artificial son protagonistas.
Con todo, técnicas clásicas como o serotipado, que permite identificar os antíxenos O e H de E. coli, seguen sendo necesarias para a caracterización inicial das cepas e mesmo para o desenvolvemento de vacinas.
-Moitos animais da nosa contorna configúranse como reservorios de cepas desta bacteria. Como leva a cabo a transmisión destas cepas ao ser humano? Como se pode intervir na cadea alimenticia para reducir a contaminación por E. coli?
-Dado que E. coli é parte da nosa microbiota intestinal e a doutros mamíferos, a principal fonte de infección é a contaminación fecal dos alimentos que consumimos. Para garantir a seguridade alimentaria, é necesario realizar controis microbiolóxicos ao longo de toda a cadea alimentaria, entendida no seu sentido máis amplo, é dicir, "da granxa á mesa".
-A resistencia aos antimicrobianos é, sen dúbida, un dos maiores retos aos que se enfronta actualmente a saúde pública mundial. Onde se están enfocando os esforzos para atallar este problema?
-Dada a magnitude do problema, están a axuntarse forzas a nivel mundial para abordalo desde unha perspectiva de "un mundo, unha soa saúde", recoñecendo que a resistencia aos antibióticos afecta á saúde global e involucra a numerosos sectores, como a medicina humana, a medicina veterinaria, a gandaría, a agricultura e a acuicultura.
Existen numerosos organismos que traballan conxuntamente para coordinar distintas estratexias, entre eles a Axencia Europea de Seguridade Alimentaria (EFSA), a Axencia Europea do Medicamento (EMA) e o Centro Europeo para a Prevención e o Control de Enfermidades (ECDC). A nivel nacional, contamos co Plan Nacional fronte á Resistencia aos Antibióticos (PRAN). Os plans de acción inclúen a elaboración de informes e recomendacións para o consumo de antibióticos, a monitorización da evolución das resistencias na poboación bacteriana, así como actividades de divulgación e investigación.
-Vostede realizou unha estancia internacional no Hôpital AP-HP Beaujon, en Francia. Que destacaría desa experiencia? Que importancia teñen, para vostede, este tipo de estancias na traxectoria dun profesional investigador?
-Da miña estancia no Hôpital AP-HP Beaujon en París, baixo a dirección da investigadora Marie-Hélène Nicolas-Chanoine, destaco o excelente trato recibido e a valiosa aprendizaxe adquirida, xa que me atopaba nos inicios da miña etapa predoutoral. No seu grupo de investigación tiven a oportunidade de estudar a formación de biofilmes en cepas de E. coli procedentes de pacientes con infeccións extraintestinales, o cal resultou nunha publicación conxunta.
As estancias no estranxeiro e a nivel nacional son moi enriquecedoras na carreira dun investigador, xa que permiten aprender novas técnicas e establecer colaboracións. Na ciencia, do mesmo xeito que noutros ámbitos, a unión e a colaboración son moi positivas.